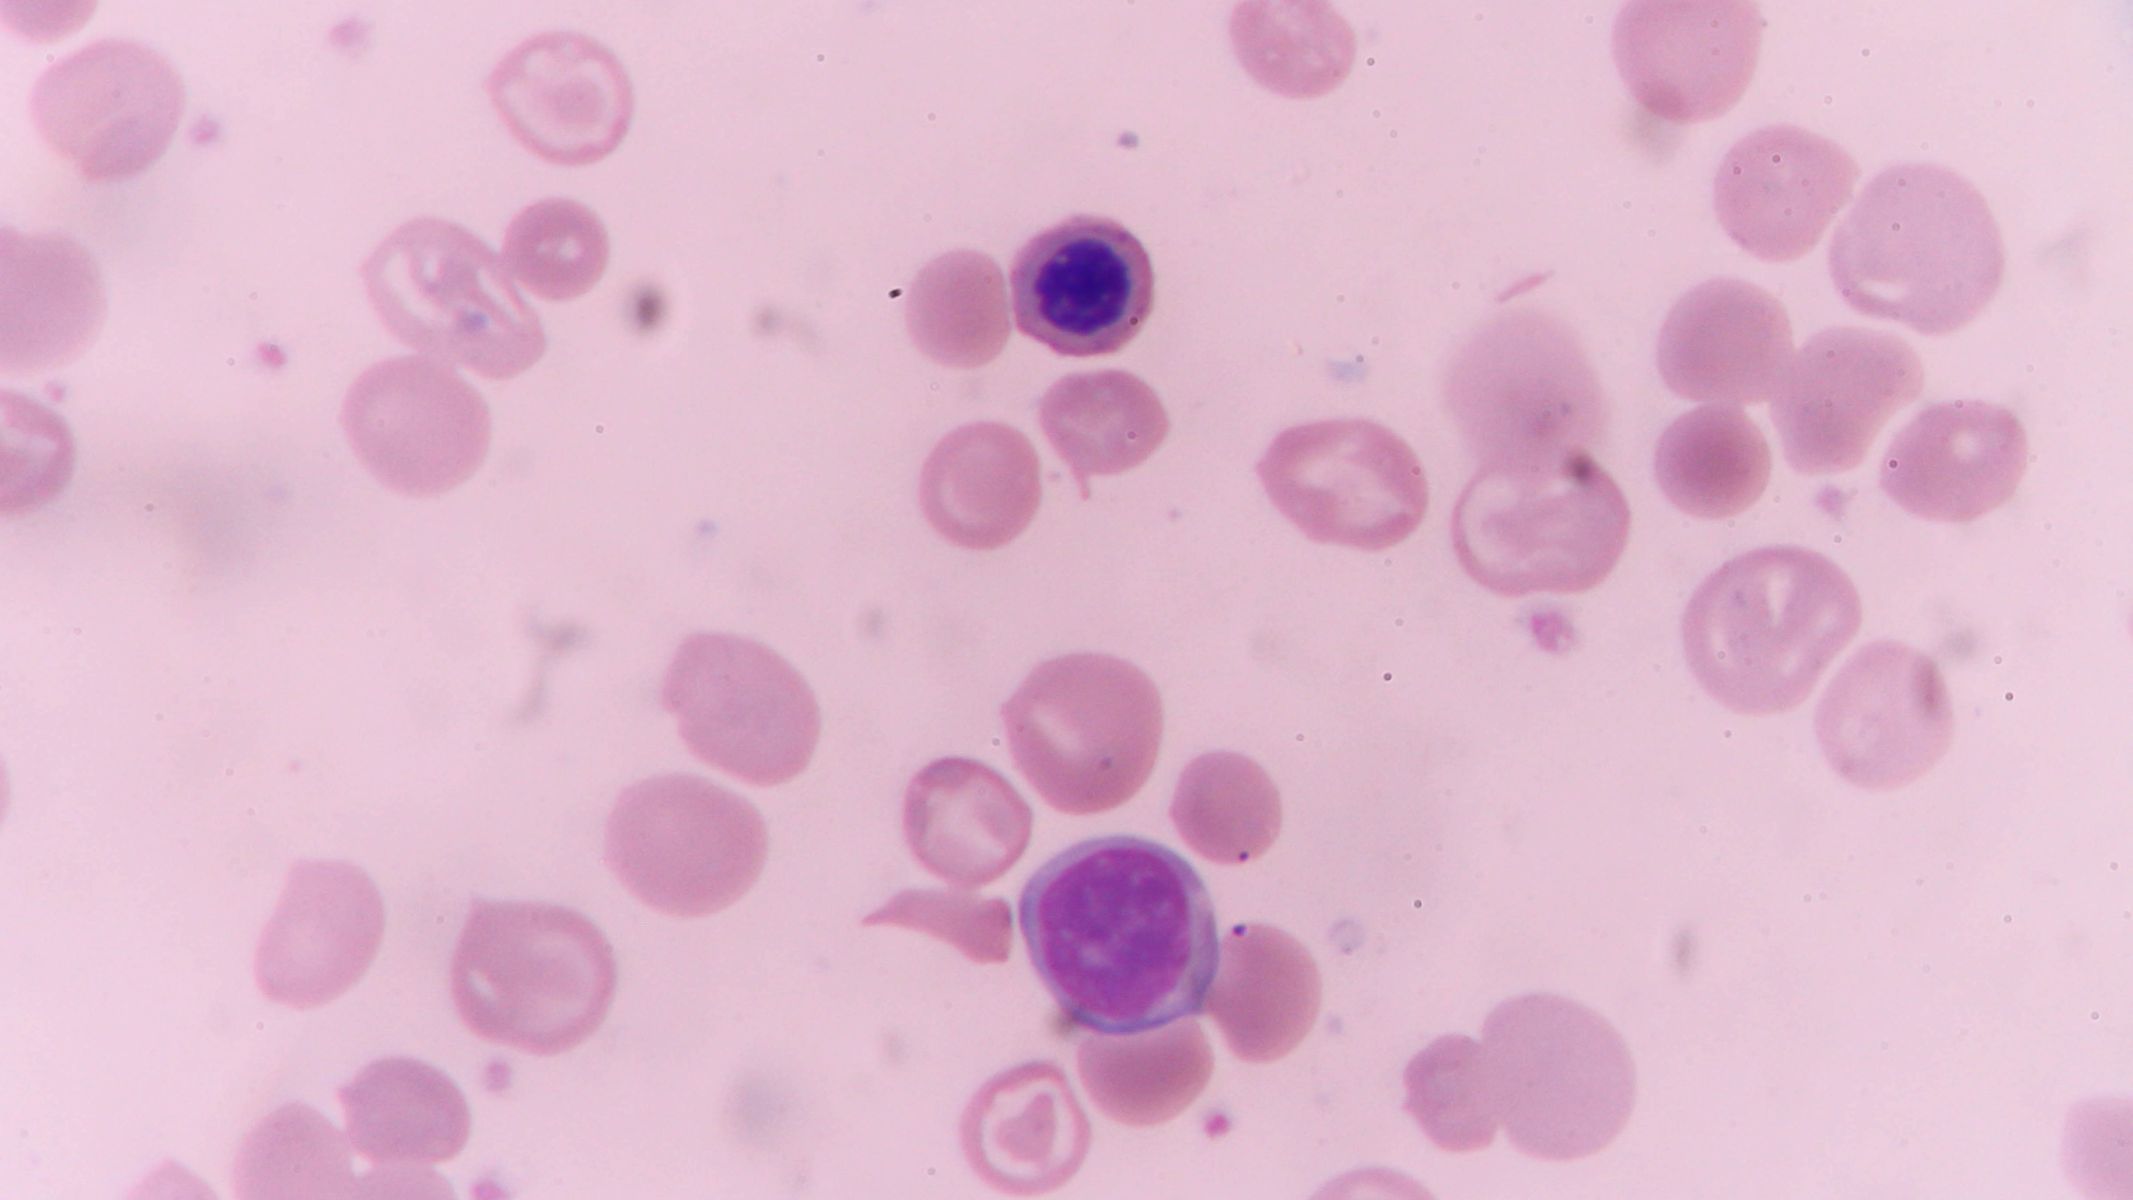
Homocysteine là gì?

Xét nghiệm máu đôi khi phát hiện những chỉ số nghe có vẻ xa lạ nhưng lại mang ý nghĩa quan trọng đối với sức khỏe tim mạch. Khi nồng độ một axit amin trung gian trong chuyển hóa tăng cao, nguy cơ tổn thương mạch máu có thể âm thầm gia tăng theo thời gian. Hiểu rõ bản chất của chỉ số này giúp người đọc tiếp cận kết quả xét nghiệm một cách chủ động và chính xác hơn.
Homocysteine là gì?
Homocysteine là một axit amin chứa lưu huỳnh được tạo ra trong quá trình chuyển hóa methionine, một axit amin thiết yếu có trong thực phẩm giàu đạm như thịt, cá, trứng và sữa. Homocysteine không tham gia trực tiếp vào cấu trúc protein của cơ thể mà tồn tại như một sản phẩm trung gian trong chu trình chuyển hóa.
Ở nồng độ sinh lý, homocysteine tham gia vào chu trình methyl hóa, một quá trình quan trọng liên quan đến tổng hợp DNA và điều hòa hoạt động tế bào. Điều này cho thấy bản thân chất này không phải là yếu tố gây hại ngay từ đầu.
Vấn đề chỉ phát sinh khi nồng độ trong máu tăng kéo dài. Khi vượt ngưỡng an toàn, homocysteine có thể tác động tiêu cực lên thành mạch máu và hệ tuần hoàn. Do đó, đánh giá chỉ số này có ý nghĩa trong phòng ngừa bệnh tim mạch hơn là điều trị một bệnh lý độc lập.
Tăng homocysteine có nguy hiểm không?
Nhiều nghiên cứu cho thấy nồng độ homocysteine tăng có liên quan đến nguy cơ bệnh tim mạch và đột quỵ.
Cơ chế gây tổn thương mạch máu
Nồng độ homocysteine cao có thể gây tổn thương lớp nội mô, tức lớp tế bào lót bên trong thành mạch máu. Lớp nội mô giữ vai trò duy trì sự trơn láng của lòng mạch và điều hòa quá trình đông máu. Khi bị tổn thương, thành mạch trở nên dễ bị viêm và hình thành mảng xơ vữa.
Bên cạnh đó, homocysteine tăng cao còn thúc đẩy quá trình oxy hóa và tạo điều kiện cho tiểu cầu kết dính. Điều này làm tăng nguy cơ hình thành cục máu đông trong lòng mạch. Nếu cục máu đông xuất hiện tại động mạch vành, nguy cơ nhồi máu cơ tim tăng lên. Nếu xảy ra tại mạch máu não, đột quỵ có thể xuất hiện.

Nhóm đối tượng dễ tăng homocysteine
Một số nhóm đối tượng có nguy cơ tăng homocysteine cao hơn người bình thường. Người lớn tuổi thường có xu hướng giảm hấp thu vitamin B12, từ đó ảnh hưởng đến chuyển hóa. Người hút thuốc lá hoặc sử dụng rượu bia kéo dài cũng có nguy cơ rối loạn chuyển hóa vitamin nhóm B.
Ngoài ra, người mắc bệnh thận mạn tính có thể giảm khả năng đào thải homocysteine. Phụ nữ mang thai thiếu acid folic cũng có thể ghi nhận chỉ số tăng. Việc xác định nhóm nguy cơ giúp định hướng theo dõi phù hợp.
Nguyên nhân khiến homocysteine tăng cao
Thiếu hụt vitamin nhóm B
Vitamin B6, B12 và acid folic đóng vai trò then chốt trong chuyển hóa homocysteine. Khi cơ thể thiếu hụt một trong các vitamin này, quá trình chuyển đổi bị gián đoạn và dẫn đến tích tụ.
Thiếu vitamin có thể xuất phát từ chế độ ăn nghèo dinh dưỡng, rối loạn hấp thu hoặc bệnh lý đường tiêu hóa. Ở người cao tuổi, khả năng hấp thu vitamin B12 giảm dần theo thời gian.

Yếu tố di truyền
Một số đột biến gen, đặc biệt liên quan đến enzym MTHFR, có thể làm giảm hiệu quả chuyển hóa homocysteine. Những trường hợp này thường có xu hướng tăng chỉ số dù chế độ ăn không thiếu vitamin rõ rệt.
Yếu tố di truyền không phải lúc nào cũng gây bệnh nhưng có thể làm tăng nguy cơ khi kết hợp với lối sống không lành mạnh.
Lối sống và bệnh lý nền
Hút thuốc lá, ít vận động và chế độ ăn thiếu rau xanh có thể góp phần làm tăng homocysteine. Người mắc suy thận mạn tính có thể giảm khả năng thải trừ chất này khỏi cơ thể.
Một số thuốc cũng có thể ảnh hưởng đến chuyển hóa vitamin nhóm B, từ đó làm tăng nồng độ trong máu. Vì vậy, việc khai thác tiền sử dùng thuốc là cần thiết khi đánh giá chỉ số bất thường.
Khi nào cần thực hiện xét nghiệm homocysteine?
Khi nào nên xét nghiệm?
Xét nghiệm homocysteine có thể được chỉ định ở người có tiền sử bệnh tim mạch sớm, đột quỵ không rõ nguyên nhân hoặc có nhiều yếu tố nguy cơ như tăng huyết áp và rối loạn mỡ máu. Trong một số trường hợp, bác sĩ có thể chỉ định khi nghi ngờ thiếu hụt vitamin B12 hoặc acid folic.

Xét nghiệm được thực hiện thông qua lấy máu tĩnh mạch. Người bệnh có thể được yêu cầu nhịn ăn trong một số trường hợp để đảm bảo độ chính xác.
Giá trị tham chiếu và ý nghĩa
Ở người trưởng thành khỏe mạnh, nồng độ homocysteine thường nằm dưới ngưỡng 15 micromol trên lít. Mức tăng nhẹ có thể không gây triệu chứng rõ ràng nhưng vẫn cần theo dõi nếu kéo dài.
Mức tăng trung bình hoặc cao hơn có thể liên quan đến nguy cơ tim mạch cao hơn. Tuy nhiên, kết quả cần được phân tích cùng với các yếu tố khác như cholesterol, huyết áp và tiền sử gia đình.
Có cần điều trị khi tăng homocysteine?
Không phải mọi trường hợp tăng đều cần điều trị bằng thuốc đặc hiệu. Trong nhiều tình huống, bổ sung vitamin nhóm B và điều chỉnh chế độ ăn có thể giúp cải thiện chỉ số.
Việc tăng cường rau xanh, ngũ cốc nguyên hạt và thực phẩm giàu vitamin B12 có thể hỗ trợ quá trình chuyển hóa. Người bệnh cần tuân thủ hướng dẫn của bác sĩ và tái kiểm tra định kỳ để đánh giá hiệu quả.
Homocysteine là gì? Đây là một axit amin trung gian trong chuyển hóa, có vai trò sinh lý bình thường nhưng có thể trở thành yếu tố nguy cơ khi tăng cao kéo dài. Việc hiểu rõ bản chất, nguyên nhân và cách theo dõi giúp người đọc chủ động hơn trong phòng ngừa bệnh tim mạch. Khi được phát hiện sớm và kiểm soát đúng cách, nồng độ homocysteine có thể được điều chỉnh thông qua dinh dưỡng và thay đổi lối sống, góp phần bảo vệ sức khỏe tim mạch lâu dài.
:format(webp)/Desktop_da87817305.png)
:format(webp)/Mobile_1_0b0c1a773a.png)
/tiem_vac_xin_sot_xuat_huyet_co_can_xet_nghiem_truoc_73e38a1f31.png)
/cach_hieu_dinh_luong_glucose_mau_va_cham_soc_suc_khoe_duong_huyet_4_4a31919395.png)
/6_ee71ee3ce4.png)
/xet_nghiem_tck_la_gi_vai_tro_trong_roi_loan_dong_mau_558bed99c2.jpg)
/Phenylalanine_la_gi_loi_ich_tac_dung_va_luu_y_quan_trong_609a8197a6.jpg)